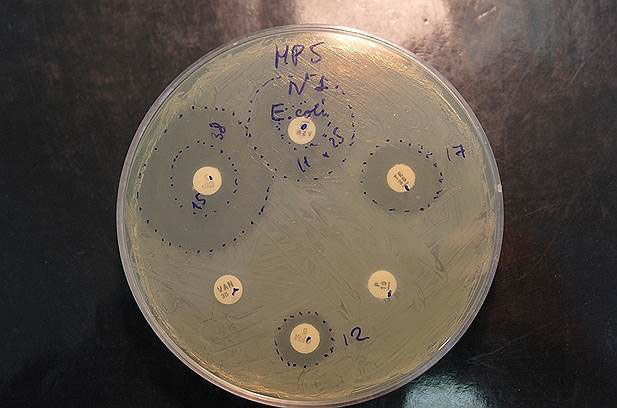
Выращивание кишечных микробов («Коммерсантъ Наука» №4, июнь 2017)

Александр Тяхт, кандидат биологических наук, старший научный сотрудник лаборатории биоинформатики Федерального научно-клинического центра физико-химической медицины
Татьяна Небольсина, Московский физико-технический институт
«Коммерсантъ Наука» №4, июнь 2017
Коллектив ученых из московского Физтеха, Федерального научно-клинического центра физико-химической медицины и Data Laboratory создал интерактивную мировую карту лекарственной устойчивости микробиоты кишечника человека — ResistoMap.
Интернет-ресурс дает возможность исследователям визуально оценивать уровень устойчивости у населения стран мира и сопоставлять его с социоэкономическими и клиническими факторами. Это позволит поднять контроль за нарастающей лекарственной устойчивостью на качественно новый уровень.
Микрофлора (микробиота, или микробиом) человека — это совокупность всех микробов, населяющих тело человека. Больше всего бактерий в кишечнике — десять триллионов, что сопоставимо с числом клеток нашего тела (они меньше, поэтому компактно размещаются у нас в животе). Кишечная микробиота одна из самых важных для жизни человека, она помогает в пищеварении, защищает от болезнетворных бактерий, участвует в работе иммунной, эндокринной и даже нервной системы. По сути это еще один орган человека, только состоящий не из человеческих, а микробных клеток.
Прочтение генетической информации всех бактерий кишечника (их метагенома) показало, что у двух случайно выбранных людей могут диаметрально различаться составы кишечных сообществ, но их общая сумма будет обеспечивать схожий набор функций. Судя по анализу микробных генов, различных функций в микробиоте закодировано на два порядка больше, чем в геноме человека. Внутри себя каждый из нас носит настоящую биофабрику, способную к переработке и синтезу множества активных веществ.
При приеме антибиотиков человеком в его организме выживают те бактерии, которые несут гены, наделяющие их защитой от антибиотиков (гены лекарственной устойчивости). Весь набор генов лекарственной устойчивости в микробиоте называется резистомом. Получается, что, принимая антибиотики, человек проводит у себя в кишечнике искусственный отбор на повышение резистома кишечного сообщества микробов.

Казалось бы, в чем проблема? Ведь это всего лишь наша нормофлора, обычные бактерии, в большинстве полезные. Но если чувствительная к антибиотику «плохая» бактерия, возбудитель инфекции, встретится с нормальной, то может позаимствовать у последней эти гены устойчивости (за счет горизонтального переноса генов). И стать «очень плохой», потому что теперь от нее не вылечиться данным лекарством. Описанная встреча может произойти в кишечнике не того человека, который лечился антибиотиком, а другого или во внешней среде — бактериям свойственно передаваться от человека к человеку.
Прием антибиотика, вынутого наугад из домашней аптечки, не только может навредить самому человеку, но и вносит вклад в укрепление резистентности патогенов в масштабах всего мира
Антибиотики попадают к кишечным микробам не только в виде лекарств. Они применяются с 1950-х годов в сельском хозяйстве как стимулятор роста для скота. Вместе с мясом и молоком в наш организм попадают и малые дозы антибиотиков, которые тоже вносят вклад в расширение репертуара генов лекарственной устойчивости. Вегетарианство не спасет: как антибиотики, так и бактерии, устойчивые к ним, могут попадать к нам с овощами, которые удобряют навозом от скота, накормленного антибиотиками.
Выращивание отдельных кишечных микробов показывает, что после приема антибиотиков начинают преобладать микробы с более широким спектром устойчивости
Похожая картина наблюдается и в других микробиомных популяциях в нашем организме: в дыхательных органах, мочеполовой системе и других. А в итоге получается, что, принимая антибиотики, каждый из нас и человечество в целом повышает вероятность появления superbugs — суперпатогенных микробов, коллекционеров генов устойчивости, против которых бессильны все известные виды антибиотиков. Сейчас по всему миру ведется множество исследований, направленных на то, чтобы побороть растущую лекарственную устойчивость.
Распространенные заблуждения относительно антибиотиков
- 64% полагают, что антибиотиками можно лечить простуду и грипп, хотя антибиотики на вирусы не действуют.
- 32% полагают, что с улучшением самочувствия следует прекратить прием антибиотиков, а не завершать предписанный курс лечения.
- 76% полагают, что устойчивость к антибиотикам наступает в результате формирования в организме резистентности к антибиотикам. В действительности же бактерии, а не люди или животные становятся устойчивыми к антибиотикам и их распространение вызывает трудноизлечимые инфекции.
- 66% полагают, что индивидуумы не подвергаются риску заразиться устойчивой к антибиотикам инфекцией, если они лично принимают антибиотики, как это им предписано.
- 44% считают, что устойчивость к антибиотикам является проблемой лишь для тех, кто их регулярно принимает. В действительности любой человек любого возраста в любой стране может заразиться устойчивой к антибиотикам инфекцией.
- 64% полагают, что медики решат эту проблему до того, как она станет слишком серьезной.
- 73% считают, что фермеры должны давать меньше антибиотиков животным, употребляемым в пищу.
По данным опроса ВОЗ, проведенного 2015 году среди 10 тыс. респондентов в 12 странах.
У каждого из нас свой состав кишечного сообщества микробов со своим набором генов устойчивости. При этом он варьирует у населения из разных социальных групп и стран. Выращивать в лаборатории отдельно каждый из тысяч видов микробов и выяснять, к каким антибиотикам он устойчив — невыполнимая на практике задача. Более того, один и тот же вид микробов у разных людей может обладать разным профилем устойчивости. С другой стороны, прочтение всей генетической информации микробиоты человека — метагеномное ДНК-секвенирование — дает общую картину того, какие гены устойчивости есть, и позволяет понять, как патогены снабжаются генами резистентности.

Проверить каждый из тысяч видов микробов на устойчивость к каждому антибиотику практически невозможно
Наша исследовательская группа исходила из того, что чем больше у определенной группы населения уровень и разнообразие резистома, тем больше вероятность возникновения в этом сообществе новых устойчивых возбудителей заболеваний, почерпнувших гены резистентности от кишечной микробиоты. Надо лишь собрать все имеющиеся на сегодня данные по кишечным метагеномам в единый реестр, доступный не только научному сообществу, но и практикующим врачам, максимально наглядный и удобный в работе с ним. Так появилась наша карта ResistoMap.
В 2016 году китайские ученые сообщили, что у детей, которых лечили от ожирения цельнозерновой диетой, в микробиоте кишечника снижались разнообразие и уровень генов устойчивости. Как предполагают исследователи, избыток пищевых волокон давал конкурентное преимущество кишечным микробам, менее склонным к носительству генов устойчивости
Большинство исследований в мире в этой области проводятся на государственные деньги, и обычно полученные на деньги налогоплательщиков результаты авторы обязаны выложить в открытый доступ. Поэтому всевозможные замеры процессов и генетической информации о живых организмах оказываются на специальных сайтах, откуда их может взять каждый желающий. Благодаря этому нам удалось собрать и объединить метагеномные данные, полученные в одинаковом формате в разных исследованиях микробиоты кишечника лабораториями со всего мира. Оставалось провести метаанализ — обработав их единообразно и совместив на общей карте, показав таким образом разнообразие генов устойчивости в кишечнике у сотен людей со всего мира.
Карта ResistoMap размещена на общедоступном сайте. На карте мира отображается средний уровень устойчивости, а ниже — на клетчатом графике, диаграмме интенсивности (heatmap) — более детальная информация: резистом по группам антибиотиков. Пользователь может фильтровать и группировать данные по возрасту, странам, диагнозу. Это позволяет сформировать нужный исследователю срез большого мирового массива данных и проанализировать закономерности в выборке.
Используя ResistoMap, можно оценить, как варьирует потенциал резистентности к различным антибиотикам в мире, и изучить связи с социоэкономическими и клиническими факторами
Код программного обеспечения прозрачен и общедоступен. После публикации научной статьи о ресурсе его уже начали использовать ученые из других стран. Сейчас на карту нанесены данные по населению из 15 стран мира, но ожидается пополнение: разработчики пригласили всех пользователей ресурса принять участие и добавить свои данные на карту, чтобы совместно сделать карту более информативной для понимания общей картины распространения устойчивости через микробиоту в мировом масштабе и полезной в практическом плане. Как говорит сотрудник нашего исследовательского коллектива Константин Ярыгин, «наш инструмент подскажет исследователям новые идеи, как оптимизировать схемы применения антибиотиков в медицине, а также в сельском хозяйстве».
Среди рассматриваемых сейчас средств альтернатив антибиотикам — фаговая терапия, при которой бактерий убивают их вирусы; бактериоцины — вещества, которые бактерии используют в войнах между собой, к ним устойчивость не возникает. Предлагается и оригинальный метод натравливать на патогенных микробов бактерий-хищников, в огромном мире микробов встречаются и такие
Параллельно с разработкой карты биоинформатики создали алгоритмы анализа метагеномных данных, которые позволили отследить, как гены устойчивости кочуют между геномами разных кишечных микробов у одного и того же пациента в ходе антибиотикотерапии. А микробиологи выделили отдельные виды из микробиоты и показали, как микробный вид, чувствительный к антибиотику, сменяется своей устойчивой разновидностью после курса лечения. В перспективе анализ кишечного резистома отдельно взятого человека позволит персонализироовать курс приема антибиотиков.
Работа проведена в рамках проекта «Оценка вариабельности резистома микробиоты кишечника у жителей РФ для обнаружения путей передачи и распространения антибиотикорезистентности» при финансовой поддержке Российского научного фонда (проект № 15-14-00066).
Все существующие антибиотики объединены в 16 классов. Так, пенициллин, первый антибиотик, открытый в 1928 году Александром Флемингом, принадлежит к классу бета-лактамных антибиотиков. Но используются лишь не более 5% антибиотиков, так как большинство из них стали бесполезны из-за антибиотикорезистентности